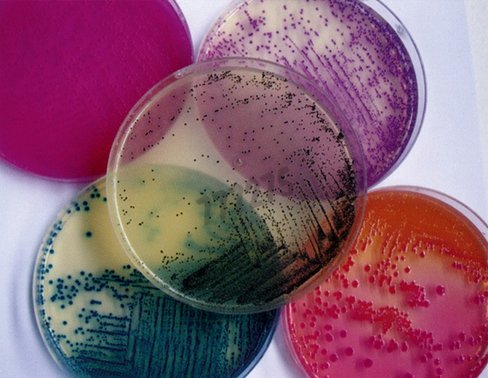
Milieu déshydraté gelose au fer de kliger (iso 500 g

Microbiologie
9089 produits - Trié par pertinence
Multishot flexplate mach1 t1r competent cells-1 x 96 well plate (20 l/well) 1 pcs
Réf. UGAP : 3649628 Réf. constructeur : C8681201
Seraseq ffpe tumor mutational burden (tmb) reference material score 22 x 10 um 20 µmol
Réf. UGAP : 3712211 Réf. constructeur : SER0710-1307
Souche quanti-culticontrol salmonella enterica atcc 14028 1 pcs
Réf. UGAP : 3664435 Réf. constructeur : 89531
Souche quanti-culticontrol streptococcus pyogenes atcc 19615 1 pcs
Réf. UGAP : 3664481 Réf. constructeur : 89538